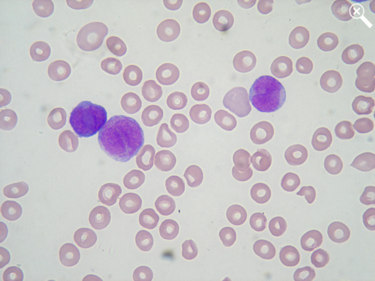

Paciente:
E.P.; 46 anos, sexo masculino
Hemograma
(Fig. 26.1 e 26.2):
Eritrograma
Hemácias (milhões/mm3): 2,48
Hemoglobina (g/dl).........: 7,1
Hematócrito (%).............: 23,5
VCM (fl) ........................: 94,8
HCM (pg)) .....................: 28,6
CHCM (g/dl)...................: 30,2
RDW (%) .....................: 26,2
Hematoscopia:
Eritroblastos (4 para 100 leucócitos )
Anisocitose (++)
Macrocitose (++)
Hipocromia (++)
Policromasia (++)
Pecilocitose (+)
Ovalócitos (+)
Leucograma
Leucócitos (mm3): 13.800
% mm3
Blastos 39,0 5.382
Bastonados 7,0 966
Segmentados 29,0 4.002
Eosinófilos 1,0 138
Linfócitos 19,0 2.622
Monócitos 5,0 690
Plaquetas: 282.000/mm3 |
|
    |
|
Figura 26.1: Sangue periférico com presença de mieloblastos.
|

|
Figura 26.2: Sangue periférico com presença de mieloblastos.
|
|
|